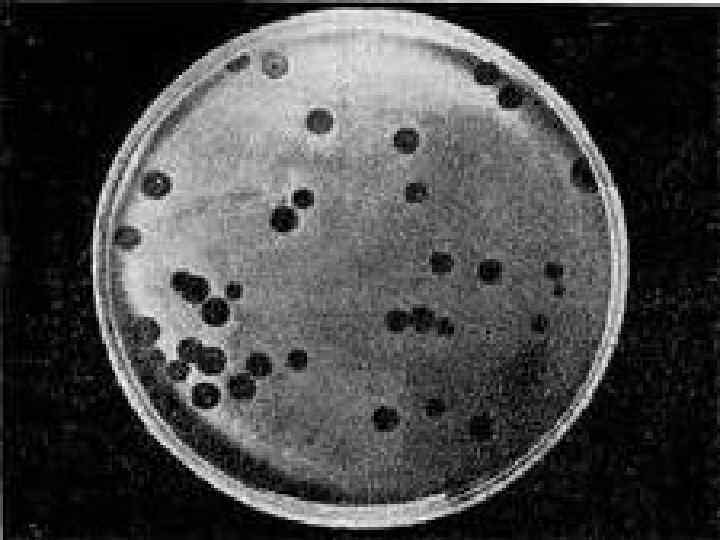
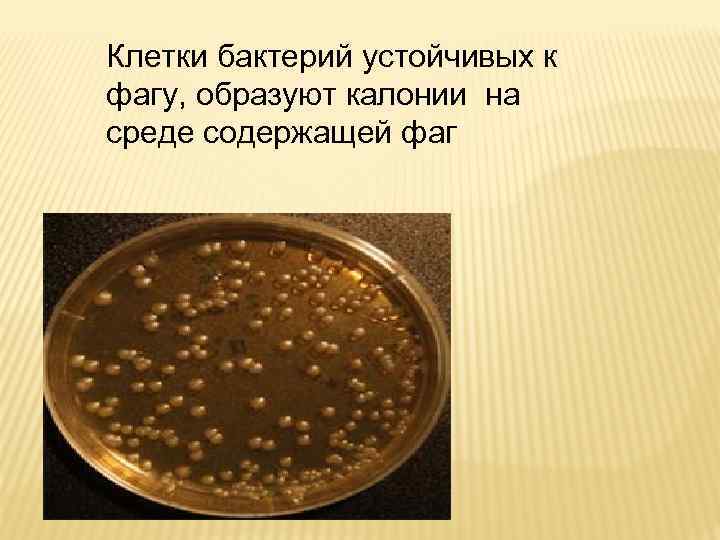
Клетки бактерий устойчивых к фагу, образуют калонии на среде содержащей фаг

вирусология,.pptx
- Количество слайдов: 32
 Вирусология (лат. vіrus – у және грек. logos – ілім), в и р о л о г и я, и н ф р а м и к р о б и о л о г и я – вирустар туралы ғылым.
Вирусология (лат. vіrus – у және грек. logos – ілім), в и р о л о г и я, и н ф р а м и к р о б и о л о г и я – вирустар туралы ғылым.
 Вирусология вирустардың табиғатын, олардың құрылысын, көбеюін, биохимиясын, генетикасын зерттейді В. вирустардың тұқым қуалаушылық қасиеттерін зерттейтін ғылым – молекулалық генетикамен тығыз байланысты. В-лық зерттеулер Қазақстанда Қазақ эпидемиол. , микробиол. және гигиена ғылыми-зертттеу институтында (қазіргі Гигиена және эпидемиол. ғылыми-зертттеу орталығы) вирус-риккетсия лабораториясы (1954 ж. ) және Қазақстан Ғылыми Академиясының Микробиология және вирусология институтында жалпы вирусология лабораториясы (1956 ж. ) ашылғаннан кейін басталды.
Вирусология вирустардың табиғатын, олардың құрылысын, көбеюін, биохимиясын, генетикасын зерттейді В. вирустардың тұқым қуалаушылық қасиеттерін зерттейтін ғылым – молекулалық генетикамен тығыз байланысты. В-лық зерттеулер Қазақстанда Қазақ эпидемиол. , микробиол. және гигиена ғылыми-зертттеу институтында (қазіргі Гигиена және эпидемиол. ғылыми-зертттеу орталығы) вирус-риккетсия лабораториясы (1954 ж. ) және Қазақстан Ғылыми Академиясының Микробиология және вирусология институтында жалпы вирусология лабораториясы (1956 ж. ) ашылғаннан кейін басталды.

 Адам ағзасына енуі жасуша вирион+вирион……. Вирион а. РНҚ т. РНҚ р. РНҚ Вирус
Адам ағзасына енуі жасуша вирион+вирион……. Вирион а. РНҚ т. РНҚ р. РНҚ Вирус

 Морфологиясы Вирустардың пішіні әр түрлі (мысалы, таяқша, иілгіш жіпше тәрізді, сфералық, көп қырлы, тағыда басқа). Вирустың клеткадан тыс (вириондар) және клетка ішінде тіршілік ететін топтары бар. Барлық вирустар шартты түрде жай және күрделі болып бөлінеді. Жай вирустар – нуклеин қышқылдары мен белокты қабықтан (капсид) тұрады; бұларға таяқша, жіп және сфералық формалары жатады. Күрделі вирустар – нуклеин қышқылы мен капсидтен басқа, липопротеидті мембрана, көмірсу және ферменттерден тұрады.
Морфологиясы Вирустардың пішіні әр түрлі (мысалы, таяқша, иілгіш жіпше тәрізді, сфералық, көп қырлы, тағыда басқа). Вирустың клеткадан тыс (вириондар) және клетка ішінде тіршілік ететін топтары бар. Барлық вирустар шартты түрде жай және күрделі болып бөлінеді. Жай вирустар – нуклеин қышқылдары мен белокты қабықтан (капсид) тұрады; бұларға таяқша, жіп және сфералық формалары жатады. Күрделі вирустар – нуклеин қышқылы мен капсидтен басқа, липопротеидті мембрана, көмірсу және ферменттерден тұрады.


 Физиологиялық қасиеті Вирустар- олар тек белгілі органдар клеткаларында және клетка ішіндегі органеллаларда өніп-өседі. Вирустар клетка ішіндегі ядрода, ядрошықтар мен рибосомдарда, митохондрияларда. Ал сонымен бірге вирустарда тірі жандар дүниесінде жоқ қасиеттер де кездеседі: вирустардың кристалл ретінде болуы, кебеюінің ерекшеліктері (дисьюнктивті түрі), нуклеин қышқылының бір түрінің ғана кездесуі. Тіпті вирустар қоректенбейді, қозғалмайды, тыныс алмайды, ештеңе бөлмейді. Осының бәрі вирустардың өлі және тірі дүние арасында тұратынын дәлелдейді Вирустар тек қана клетка ішінде өсіп жетілетін арамтамақтар және бір иеден екінші иеге ауысып отырады
Физиологиялық қасиеті Вирустар- олар тек белгілі органдар клеткаларында және клетка ішіндегі органеллаларда өніп-өседі. Вирустар клетка ішіндегі ядрода, ядрошықтар мен рибосомдарда, митохондрияларда. Ал сонымен бірге вирустарда тірі жандар дүниесінде жоқ қасиеттер де кездеседі: вирустардың кристалл ретінде болуы, кебеюінің ерекшеліктері (дисьюнктивті түрі), нуклеин қышқылының бір түрінің ғана кездесуі. Тіпті вирустар қоректенбейді, қозғалмайды, тыныс алмайды, ештеңе бөлмейді. Осының бәрі вирустардың өлі және тірі дүние арасында тұратынын дәлелдейді Вирустар тек қана клетка ішінде өсіп жетілетін арамтамақтар және бір иеден екінші иеге ауысып отырады


 Дақылдануы • Вирустарды үш биологиялық үлгілерде дақылдандырады, олар зертханалық жануарлар организмінде қүстардың дамып келе жатқан эмбрионинде және де жасушада дақылдандырады. Вирустарды дақылдау үшін вирус материалын амниоттың аллантойсты орта қуыс, сары уыз қапшық, венаға, эмбрион денесіне аллонтойс мембранасына егеді
Дақылдануы • Вирустарды үш биологиялық үлгілерде дақылдандырады, олар зертханалық жануарлар организмінде қүстардың дамып келе жатқан эмбрионинде және де жасушада дақылдандырады. Вирустарды дақылдау үшін вирус материалын амниоттың аллантойсты орта қуыс, сары уыз қапшық, венаға, эмбрион денесіне аллонтойс мембранасына егеді


 ДАЯРЛАУ ТЕХНИКАСЫНА БАЙЛАНЫСТЫ БІРҚАБАТТЫ, СУСПЕНЗИЯЛЫҚ ЖӘНЕ АҒЗАЛЫҚ ЖАСУША ДАҚЫЛДАРЫН АЖЫРАТАДЫ: • БІРҚАБАТТЫ ЖАСУША ДАҚЫЛДАРЫ - ХИМИЯЛЫҚ БЕЙТАРАП ЗЕРТХАНАЛЫҚ ЫДЫСТЫҢ ШЫНЫСЫНЫҢ БЕТІНЕ ЖАБЫСЫП БІРҚАБАТТТАНЫП ӨСУГЕ ҚАБІЛЕТТІ. БУЛАРДЫ ВИРУСОЛОГИЯДА ЖИІРЕК ПАЙДАЛАНАДЫ. • СУСПЕНЗИЯЛЫҚ ЖАСУША ДАҚЫЛДАРЫ - ЖАСУШАЛАР ҚОРЕКТІК ОРТАНЫҢ БАРЛЫҚ КӨЛЕМІНДЕ ТҰРАҚТЫ ТҮРДЕ МАГНИТТІК АРАЛАСТЫРҒЫШПЕН ШАЙҚАП НЕМЕСЕ АЙНАЛМАЛЫ БАРАБАННЫҢ ІШІНДЕ КӨБЕЙТЕДІ. БҰЛАРДЫ ЖАСУШАЛАРДЫҢ МОЛ МӨЛШЕРІН АЛУ ҮШІН, МЫСАЛЫ, ӨНДІРІСТЕ ВИРУСТЫҚ ВАКЦИНАЛАРДЫ АЛУДА ПАЙДАЛАНАДЫ. • АҒЗАЛЫҚ ДАҚЫЛДАР - АҒЗАЛАР МЕН ТІНДЕРДІҢ ОРГАНИЗМНЕН ТЫС ЖЕРДЕ БАСТАПҚЫ ҚҰРЫЛЫМЫН САҚТАЙТЫН БҮТІНДЕЙ БӨЛШЕКТЕРІ (ШЕКТЕУЛІ ҚОЛДАНЫЛАДЫ
ДАЯРЛАУ ТЕХНИКАСЫНА БАЙЛАНЫСТЫ БІРҚАБАТТЫ, СУСПЕНЗИЯЛЫҚ ЖӘНЕ АҒЗАЛЫҚ ЖАСУША ДАҚЫЛДАРЫН АЖЫРАТАДЫ: • БІРҚАБАТТЫ ЖАСУША ДАҚЫЛДАРЫ - ХИМИЯЛЫҚ БЕЙТАРАП ЗЕРТХАНАЛЫҚ ЫДЫСТЫҢ ШЫНЫСЫНЫҢ БЕТІНЕ ЖАБЫСЫП БІРҚАБАТТТАНЫП ӨСУГЕ ҚАБІЛЕТТІ. БУЛАРДЫ ВИРУСОЛОГИЯДА ЖИІРЕК ПАЙДАЛАНАДЫ. • СУСПЕНЗИЯЛЫҚ ЖАСУША ДАҚЫЛДАРЫ - ЖАСУШАЛАР ҚОРЕКТІК ОРТАНЫҢ БАРЛЫҚ КӨЛЕМІНДЕ ТҰРАҚТЫ ТҮРДЕ МАГНИТТІК АРАЛАСТЫРҒЫШПЕН ШАЙҚАП НЕМЕСЕ АЙНАЛМАЛЫ БАРАБАННЫҢ ІШІНДЕ КӨБЕЙТЕДІ. БҰЛАРДЫ ЖАСУШАЛАРДЫҢ МОЛ МӨЛШЕРІН АЛУ ҮШІН, МЫСАЛЫ, ӨНДІРІСТЕ ВИРУСТЫҚ ВАКЦИНАЛАРДЫ АЛУДА ПАЙДАЛАНАДЫ. • АҒЗАЛЫҚ ДАҚЫЛДАР - АҒЗАЛАР МЕН ТІНДЕРДІҢ ОРГАНИЗМНЕН ТЫС ЖЕРДЕ БАСТАПҚЫ ҚҰРЫЛЫМЫН САҚТАЙТЫН БҮТІНДЕЙ БӨЛШЕКТЕРІ (ШЕКТЕУЛІ ҚОЛДАНЫЛАДЫ
 Вирусы бар заттармен зақымдалған жасушалар дақылындағы вирус репродукциясын келесі көріністер (феномендер) негізінде бақылауға болады: вирустардың цитопатогенді әсері (ЦПӘ), немесе топатикалық әсері, жасушаішілік қосындылардың пайда болуы; «таңдақтардың» пайда болуы; гемадсорбция жэне агглютинация реакцияларының және «түсті» реакцияның оң нәтижелі болуы. ЦПӘ - вирустардың көбеюінің салдарынан жасушалардың морфологиялық өзгерістерінің бұзылуын микроскоппен бақылауға болады. Репродукцияланып жатқан вирустың ерекшеліктеріне байланысты ЦПӘ әртүрлі болуы мүмкін. Бір жағдайда цитоплазма тек вакуолизацияланып, митохондриялар бұзылып, жасушалар дөңгелектеніп барып өлетін болса, ал кейбір жағдайларда-көпядролы болып жасушалар (симпласттар) қалыптасады немесе нәтижесінде жасушаның деструкциясымен аяқталатын жасуша пролиферациясы байқалады. Міне осындай көріністерге байланысты ЦПӘ сипатын вирустар индикациясында ғана емес, сондай-ақ олардың жасуша дақылдарындағы болжамды идентификациясында да қолдануға болады.
Вирусы бар заттармен зақымдалған жасушалар дақылындағы вирус репродукциясын келесі көріністер (феномендер) негізінде бақылауға болады: вирустардың цитопатогенді әсері (ЦПӘ), немесе топатикалық әсері, жасушаішілік қосындылардың пайда болуы; «таңдақтардың» пайда болуы; гемадсорбция жэне агглютинация реакцияларының және «түсті» реакцияның оң нәтижелі болуы. ЦПӘ - вирустардың көбеюінің салдарынан жасушалардың морфологиялық өзгерістерінің бұзылуын микроскоппен бақылауға болады. Репродукцияланып жатқан вирустың ерекшеліктеріне байланысты ЦПӘ әртүрлі болуы мүмкін. Бір жағдайда цитоплазма тек вакуолизацияланып, митохондриялар бұзылып, жасушалар дөңгелектеніп барып өлетін болса, ал кейбір жағдайларда-көпядролы болып жасушалар (симпласттар) қалыптасады немесе нәтижесінде жасушаның деструкциясымен аяқталатын жасуша пролиферациясы байқалады. Міне осындай көріністерге байланысты ЦПӘ сипатын вирустар индикациясында ғана емес, сондай-ақ олардың жасуша дақылдарындағы болжамды идентификациясында да қолдануға болады.
 Биохимиялық қасиеті § Вирус ультракүлгін сәулелер мен химиялық заттарға (қышқыл, сілті) төзімді келеді. Тотықтырғыш заттар вирустың белсенділігін жояды, ал барлық тотықсыздандырғыш заттар олардың тіршілігіне қолайлы келеді. Мысалы, полиомиелит вирусы фенолдың 0, 5%, күкірт қышқылы аммонийдың 50%-дық ерітіндісінде сақтала береді. Ал тотықтырғыштарда, мысалы, сутек асқын тотығы немесе марганецқышқыл калий (1%) ерітіндісінде олар тіршілігін тез жояды. Тек ДНҚ немесе РНҚдан тұрады
Биохимиялық қасиеті § Вирус ультракүлгін сәулелер мен химиялық заттарға (қышқыл, сілті) төзімді келеді. Тотықтырғыш заттар вирустың белсенділігін жояды, ал барлық тотықсыздандырғыш заттар олардың тіршілігіне қолайлы келеді. Мысалы, полиомиелит вирусы фенолдың 0, 5%, күкірт қышқылы аммонийдың 50%-дық ерітіндісінде сақтала береді. Ал тотықтырғыштарда, мысалы, сутек асқын тотығы немесе марганецқышқыл калий (1%) ерітіндісінде олар тіршілігін тез жояды. Тек ДНҚ немесе РНҚдан тұрады


 Резистенттілігі § Вирустар әр түрлі сыртқы орта факторларына төзімді келеді Бағана айтып өтілгендей Вирус ультракүлгін сәулелер мен химиялық заттарға (қышқыл, сілті) төзімді келеді.
Резистенттілігі § Вирустар әр түрлі сыртқы орта факторларына төзімді келеді Бағана айтып өтілгендей Вирус ультракүлгін сәулелер мен химиялық заттарға (қышқыл, сілті) төзімді келеді.

 Тинкториальдылығы Жасуша дақылдарында вирустардың репродукцияланғанын «түсті» реакциямен де анықтауга болады. Ол жасуша дақылдарына арналған орталарға енгізген индикатор түсінің өзгеруімен тіркеледі. Егер вирустар жасуша дақылдарында көбеймесе, онда тірі жасушалар метаболизм барысында кышқыл өнімдер бөледі де ортаның рн-ын өзгертеді. Соның салдарынан индикатор түсі де өзгереді. Вирустар репродукциясы кезінде жасушалардың қалыпты метаболизмі бұзылады да (жасуша өледі) орта индикатордың алғашқы түсін сақтайды.
Тинкториальдылығы Жасуша дақылдарында вирустардың репродукцияланғанын «түсті» реакциямен де анықтауга болады. Ол жасуша дақылдарына арналған орталарға енгізген индикатор түсінің өзгеруімен тіркеледі. Егер вирустар жасуша дақылдарында көбеймесе, онда тірі жасушалар метаболизм барысында кышқыл өнімдер бөледі де ортаның рн-ын өзгертеді. Соның салдарынан индикатор түсі де өзгереді. Вирустар репродукциясы кезінде жасушалардың қалыпты метаболизмі бұзылады да (жасуша өледі) орта индикатордың алғашқы түсін сақтайды.

Клетки бактерий устойчивых к фагу, образуют калонии на среде содержащей фаг
Клетки бактерий устойчивых к фагу, образуют калонии на среде содержащей фаг
 Вирустардың негізгі ерекшеліктері 1. Вирустың қүрамында тек бір нуклеин қышқылы ғана бар: РНҚ (рибонуклеин қышқылы) немесе ДНҚ (дезо-ксирибонуклеин қышқылы). Сондықтан да вирустар құрамында РНҚ-лы немесе ДНҚлы бар вирустар болып бөлінеді. Ең негізгісі РНҚ-лы бар вирустардың барлық генетикалық ақпараты осы РНҚ-да. Мұндай жағдай биологияда тіпті де кездеспейді. 2. Вирустар тек клетка ішінде ғана тіршілік ететін арамтамақтар, демек тек клетка ішінде ғана көбейеді. 3. Вирустардың көбею ерекшеліктерін "дисьюнктивтік" түрге жатқызады. Себебі барлық жанды дүние екіге бөліну, бүршіктену, спора арқылы көбейсе, вирустардың өсіп-өнуі одан да ерекше. Вирустар клетка ішінде болады да жоғалып кетеді. Себебі вирус бөлшектерін, серологиялық не микроскоп әдістері арқылы клетка ішінен кездестіре алмаймыз, клетка ішінде белок пен нуклеин қышқылына бөлініп кетеді. Ал болашақ вирустың компоненттері клетканың әр жерінде пайда болады: нуклеин қышқылы — ядрода, цитоплазмада, белоктары — цитоплазмада, содан кейін барып вириондар кұралады. Күрделі вирустардың өсіп-жетілуі бұдан көп ерекше. Олар уақыт және кеңістікте бірнеше сатыға бөлінеді. Себебі олардың, көбеюі де бірнеше сатыдан тұрады. 4. Вирустардың белок құрайтын жүйесі — рибосомдары жоқ. Демек вирустар өздері белок құрай алмайды.
Вирустардың негізгі ерекшеліктері 1. Вирустың қүрамында тек бір нуклеин қышқылы ғана бар: РНҚ (рибонуклеин қышқылы) немесе ДНҚ (дезо-ксирибонуклеин қышқылы). Сондықтан да вирустар құрамында РНҚ-лы немесе ДНҚлы бар вирустар болып бөлінеді. Ең негізгісі РНҚ-лы бар вирустардың барлық генетикалық ақпараты осы РНҚ-да. Мұндай жағдай биологияда тіпті де кездеспейді. 2. Вирустар тек клетка ішінде ғана тіршілік ететін арамтамақтар, демек тек клетка ішінде ғана көбейеді. 3. Вирустардың көбею ерекшеліктерін "дисьюнктивтік" түрге жатқызады. Себебі барлық жанды дүние екіге бөліну, бүршіктену, спора арқылы көбейсе, вирустардың өсіп-өнуі одан да ерекше. Вирустар клетка ішінде болады да жоғалып кетеді. Себебі вирус бөлшектерін, серологиялық не микроскоп әдістері арқылы клетка ішінен кездестіре алмаймыз, клетка ішінде белок пен нуклеин қышқылына бөлініп кетеді. Ал болашақ вирустың компоненттері клетканың әр жерінде пайда болады: нуклеин қышқылы — ядрода, цитоплазмада, белоктары — цитоплазмада, содан кейін барып вириондар кұралады. Күрделі вирустардың өсіп-жетілуі бұдан көп ерекше. Олар уақыт және кеңістікте бірнеше сатыға бөлінеді. Себебі олардың, көбеюі де бірнеше сатыдан тұрады. 4. Вирустардың белок құрайтын жүйесі — рибосомдары жоқ. Демек вирустар өздері белок құрай алмайды.
 5. Вирустар — генетикалық деңгейдегі арамтамақтар. Вирустар жасанды орталарда (ЕПА, ЕПС) өспейді. Себебі оларда ассимиляция, диссимиляция, тыныс алу деген жоқ, қоректенбейді, ештеңе бөлмейді. Вирустардың көбеюі үшін тек қана тірі клетка керек, тек клетканың ішінде ғана, клетка материалдарын пайдаланып қана көбейеді 6 Вирустардың ендігі бір ерекшелігі ол өте ұсақ. Олар нанометрмен өлшенеді. 1 нм — метрдің миллиардтан бір бөлігі 1/100000 м. Демек 1 метрде - 1 000 000 нм, ал 1 мм - 1 000 нм, 1 мкм - 1 000 нм, 1 нм - 10 А°. Мысалы, ең ірі деген шешек ауруы вирусының мөлшері жөнінен бактерияға жақындайды. Үлкендігі 250 — 350 нм. Ең кіші вирустың ірілігі (мысалы, аусыл ауруын қоздыратын вирус) 20 — 30 нм. Осындай өте ұсақ вирусты тек электрондық микроскоппен ғана көруге болады. Себебі ондай микроскоп 200000 — 500000, не 1 — 2 млн рет үлкейтіп көрсетеді. Вирустардың осындай ұсақ болуына байланысты оларды зерттеу үшін сүзгіден өткізу тәсілдері қолданылады. Сондықтан да уақытында " Сүзгіден өтетін вирус" деген ұғым пайда болды. Қазіргі кезде "Вирус" деген ұғым ғана қолданылады.
5. Вирустар — генетикалық деңгейдегі арамтамақтар. Вирустар жасанды орталарда (ЕПА, ЕПС) өспейді. Себебі оларда ассимиляция, диссимиляция, тыныс алу деген жоқ, қоректенбейді, ештеңе бөлмейді. Вирустардың көбеюі үшін тек қана тірі клетка керек, тек клетканың ішінде ғана, клетка материалдарын пайдаланып қана көбейеді 6 Вирустардың ендігі бір ерекшелігі ол өте ұсақ. Олар нанометрмен өлшенеді. 1 нм — метрдің миллиардтан бір бөлігі 1/100000 м. Демек 1 метрде - 1 000 000 нм, ал 1 мм - 1 000 нм, 1 мкм - 1 000 нм, 1 нм - 10 А°. Мысалы, ең ірі деген шешек ауруы вирусының мөлшері жөнінен бактерияға жақындайды. Үлкендігі 250 — 350 нм. Ең кіші вирустың ірілігі (мысалы, аусыл ауруын қоздыратын вирус) 20 — 30 нм. Осындай өте ұсақ вирусты тек электрондық микроскоппен ғана көруге болады. Себебі ондай микроскоп 200000 — 500000, не 1 — 2 млн рет үлкейтіп көрсетеді. Вирустардың осындай ұсақ болуына байланысты оларды зерттеу үшін сүзгіден өткізу тәсілдері қолданылады. Сондықтан да уақытында " Сүзгіден өтетін вирус" деген ұғым пайда болды. Қазіргі кезде "Вирус" деген ұғым ғана қолданылады.
 10. Сыртқы ортада вирустарды вириондар деп атайды, яғни сыртқы ортадағы формасы 11. Вирустарды өлігеде тірігеде жатқызуға болмайды 12. Құрылымы қарапайым яғни оларда ядро да клеткаға тән ештеңе жоқ, вирустардың құрамы өте қарапайым: нуклеин қышқылы, белок, қант және май, тек кейбір күрделі вирустардың ғана ферменттері болады. 13. Вирустарға репликация тән Ол ДНҚның екі еселенуі арқылы жүзеге асады Құрылымы капсид, ДНҚ немесе РНҚ, ферменттерден тұрады 14. Вирустарды өсіру үшін тірі ағза керек 15. Вирустар төменгі температураға төзімді -273 t Жоғары температураға төзімсіз 45 t 16. Жасуша қабығы жоқ 17. синтездеуші жүйесі жоқ
10. Сыртқы ортада вирустарды вириондар деп атайды, яғни сыртқы ортадағы формасы 11. Вирустарды өлігеде тірігеде жатқызуға болмайды 12. Құрылымы қарапайым яғни оларда ядро да клеткаға тән ештеңе жоқ, вирустардың құрамы өте қарапайым: нуклеин қышқылы, белок, қант және май, тек кейбір күрделі вирустардың ғана ферменттері болады. 13. Вирустарға репликация тән Ол ДНҚның екі еселенуі арқылы жүзеге асады Құрылымы капсид, ДНҚ немесе РНҚ, ферменттерден тұрады 14. Вирустарды өсіру үшін тірі ағза керек 15. Вирустар төменгі температураға төзімді -273 t Жоғары температураға төзімсіз 45 t 16. Жасуша қабығы жоқ 17. синтездеуші жүйесі жоқ
 18. Нәруыз бен қапталған капситден түрады. Бұл қабықша вирустың құрамындағы нуклеин қышқылдарын сыртқы ортаның қолайсыз жағдайларынан корғайды 19. Кейбір вирустардың құрамында нуклеин қышқылдарынан басқа көмірсулар, май текті заттар, биотин (Н витамині) және мыс молекулалары кездеседі. 20. Вирустар тек тірі жасушада өніп-өсіп көбеюге бейімделген. Электрондық микроскоппен 300 мың есе үлкейтіп қарағанда, оның пішіні таяқша тәрізді, жіп тәрізді немесе іші қуыс цилиндр пішінді болатыны дәлелденд 21. барлық вирустар сүзілгіш келеді; 22. нәруыз түзетін жүйесі болмайды 23. жасанды қоректік ортада өспейді 24. Олар тек сезімтал организмдердің клетка ішіндв тіршілігін білдіртеді. Ал сыртқы ортада ешбір тіршілік белсенділігін білдірмейді.
18. Нәруыз бен қапталған капситден түрады. Бұл қабықша вирустың құрамындағы нуклеин қышқылдарын сыртқы ортаның қолайсыз жағдайларынан корғайды 19. Кейбір вирустардың құрамында нуклеин қышқылдарынан басқа көмірсулар, май текті заттар, биотин (Н витамині) және мыс молекулалары кездеседі. 20. Вирустар тек тірі жасушада өніп-өсіп көбеюге бейімделген. Электрондық микроскоппен 300 мың есе үлкейтіп қарағанда, оның пішіні таяқша тәрізді, жіп тәрізді немесе іші қуыс цилиндр пішінді болатыны дәлелденд 21. барлық вирустар сүзілгіш келеді; 22. нәруыз түзетін жүйесі болмайды 23. жасанды қоректік ортада өспейді 24. Олар тек сезімтал организмдердің клетка ішіндв тіршілігін білдіртеді. Ал сыртқы ортада ешбір тіршілік белсенділігін білдірмейді.
 Вирустардың жасушамен өзара әсерлесу механизімі Фаг клеткасымен әсер ету механизміне байланысты – вирулентті және вирулентсіз болып бөлінеді. Вирулентті фаг негізгі 4 кезеңмен әсерленеді: жабысу (адсорбция), клеткаға ену, көбею (репродукция) және фагтардың бөлініп шығуы. Клетканың бетіне фагтардың жабысуы, фагтың етек жағындағы белоктың амин тобымен бактерия клеткасының беткі қабатындағы теріс зарядталған карбоксил тобының әсерлесуі арқылы жүреді. Жабысудың қайталама және қайталамайтын түрі болады. Қайталама фаза фагты клеткадан қозғау, иондардың концентрациясын азайту арқылы бөліп алуға болады. Бұлай бөліп алған фагтар өзінің өмір сүру қабілетін сақтап қалады. Жабысу фазасы (кезеңі) орның құрамына, сұйықтығына және температурасына байланысты. Дистилді суда фагтардың жабысуы жүрмейді. Екі валетті катиондар (са++ және мg++) жабысу процесін жақсы жүргізеді. Жабысуды жақсартуда триптофан, изолейцин жақсы роль атқарады.
Вирустардың жасушамен өзара әсерлесу механизімі Фаг клеткасымен әсер ету механизміне байланысты – вирулентті және вирулентсіз болып бөлінеді. Вирулентті фаг негізгі 4 кезеңмен әсерленеді: жабысу (адсорбция), клеткаға ену, көбею (репродукция) және фагтардың бөлініп шығуы. Клетканың бетіне фагтардың жабысуы, фагтың етек жағындағы белоктың амин тобымен бактерия клеткасының беткі қабатындағы теріс зарядталған карбоксил тобының әсерлесуі арқылы жүреді. Жабысудың қайталама және қайталамайтын түрі болады. Қайталама фаза фагты клеткадан қозғау, иондардың концентрациясын азайту арқылы бөліп алуға болады. Бұлай бөліп алған фагтар өзінің өмір сүру қабілетін сақтап қалады. Жабысу фазасы (кезеңі) орның құрамына, сұйықтығына және температурасына байланысты. Дистилді суда фагтардың жабысуы жүрмейді. Екі валетті катиондар (са++ және мg++) жабысу процесін жақсы жүргізеді. Жабысуды жақсартуда триптофан, изолейцин жақсы роль атқарады.




